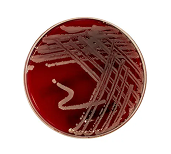
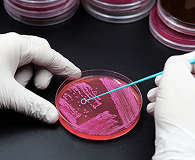

en procedimientos de rutina
Calidad y confiabilidad
Nuestros insumos están orientados al uso profesional en entornos clínicos y de laboratorio.
Abastecimiento constante
Brindamos atención personalizada y respuesta oportuna para asegurar la continuidad operativa del laboratorio.
Portafolio Especializado
Contamos con el respaldado de un sólido portafolio de clientes en Clinicas y laboratorios en el Perú.

Todo lo que necesitas para
el abastecimiento de tu laboratorio
Explora categorías de insumos para laboratorio organizadas por tipo de procedimiento, desde la toma de muestras y microbiología hasta gasometría y uso clínico.
Los insumos que
necesitas, a tu alcance
Productos esenciales para operación diaria, con enfoque en seguridad y desempeño.
Compromiso con la calidad en insumos
Abastecemos a clínicas, hospitales y técnicos microbiólogos con productos esenciales para su operación diaria.



Realiza tu consulta
Completa tus datos para una atención personalizada.
Aceptar las políticas de privacidad y términos de uso, al recibir mensajes.